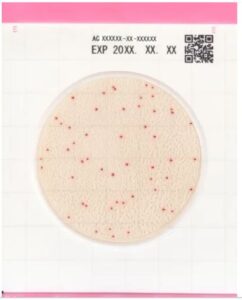
Easy-Plate-AC-Aerobik

Easy-Plate-AC-Aerobic-Count-Total-Count-Toplam-Canli
Aerobik Bakterilerin Gelişimi İçin Özel Besiyeri
Easy Plate AC, aerobik bakterilerin sayımı için AOAC sertifikalı özel, hazırlık ve sterilizasyon gerektirmeyen, kullanıma hazır ve steril besiyeridir. Kolayca ayırt edilebilen renkli kırmızı koloniler sağlayan bir kimyasal indikatör içeren mikrobiyal test kiti, aerobik bakterileri 48 saat içinde kolayca tanımlayıp saymanızı sağlar. Easy Plate AC, AOAC PTM sertifikalıdır. 25 test içeren paketler halinde satılır. 2-8°C arasında saklanır ve uzun raf ömrüne sahiptir.
Easy Plate AC, genel itibariyle, ortam hazırlama veya sterilizasyon gerektirmeyen, kullanışlı bir hazır besiyeri plakasıdır. Bununla birlikte, geleneksel plakalı ortamlar kullanılarak yapılan, klasik besiyeri hazırlama yöntemlerine, kolay kullanımlı bir alternatiftir. Zamandan, işçilikten ve plastik atıklardan tasarruf sağlar. Geleneksel petri kabının yaklaşık 1/20’si kadar olan Easy Plate’i gıda mikrobiyolojik test kiti olarak kullanmak, yerden tasarruf sağlar. Mevcut inkübatör alanınızla, daha fazla test yapmanıza olanak tanır. Easy Plate, kullanıma hazır olarak gelir. Bu sayede, paketi açtıktan hemen sonra, ortama bir numune süspansiyonu yerleştirip, inkübasyona başlayabilirsiniz.
Easy Plate AC Aerobic Count, genel itibariyle, aerobik bakterilerin yetiştirilmesi için AOAC, PTM ve Microval sertifikalı özel bir besiyeri formülüdür. Bilhassa, kolayca ayırt edilmesi için, renkli kırmızı koloniler sağlayan bir kimyasal indikatör içeren mikrobiyal test kitidir. Bu sayede, Aerobik bakterileri, 48±2 saat içinde, kolayca tanımlayıp, saymanızı sağlar. Easy Plate AC, AOAC PTM sertifikalıdır. 25 test içeren paketler halinde satılır. Özetlemek gerekirse, 2°C ile 8°C sıcaklık aralığında, paket açılmadan saklandığında, raf ömrü, 18 aydır.
(Açtıktan Sonra): Paketi açtıktan sonra paketin açık ucunu en az 2 kez katlayıp bantlayınız. Buzdolabında (2 ila 8°C) saklayın ve 3 ay içinde kullanın.
Raf Ömrü: Üretim tarihinden itibaren 18 ay
Kod: 61973

EASY PLATE COLONY COUNTER SCAN SYSTEM AND SOFTWARE
iNKüBASYON SüRESi: 48 ± 2 saat; 35 ± 1℃ sıcaklık
ÜRETiCi FiRMA LiNKi: https://biochemifa.kikkoman.com/e/products/detail/?id=13240

EASY PLATE AC AMBALAJ
https://skalateknik.com/kikkoman-lumitester-smart-hijyen-monitoru/
Skala Teknik
Typically replies within minutes
Any questions related to EASY PLATE – AC – AEROBiC COUNT – TOPLAM CANLI – HAZIR BESiYERi – JAPON KiKKOMAN TEKNOLOJiSi?
WhatsApp Us
🟢 Online | Privacy policy
